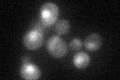
YJR147W
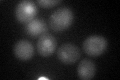
YJR147W

View description
Protein with similarity to heat shock transcription factors; overexpression suppresses the pseudohyphal filamentation defect of a diploid mep1 mep2 homozygous null mutant
Localization:
Intensity:
Fold change:
Significance:
-
C’ GFP library in SD
nucleus:cytosol29.59 -
N' NOP1pr-GFP in SD

nucleus38.464 -
N' TEF2pr-mCherry in SD

punctate,nucleus26.2706 -
N' NATIVEpr-GFP in SD

below threshold18.5216 -
N' TEF2pr-VC and Cyto-VN in SD

below threshold26.7053 -
C’ GFP library in SD+DTT
nucleus.cytosol22.230.75No -
C’ GFP library in SD+H2O2

nucleus.cytosol31.111.05No -
C’ GFP library in Starvation Media

nucleus,cytosol30.621.03No -
C’ GFP library on the background of Pup2-DaMP

nucleus:cytosol -
C’ GFP library on the background of CCT mutant

nucleus:cytosol26.56090.89761No
